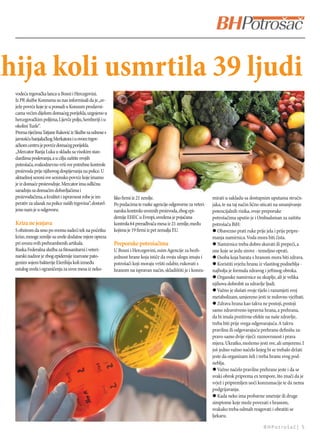
ihija koli usmrtila 39 ljudi
  vodeća trgovačka lanca u Bosni i Hercegovini.
  Iz PR službe Konzuma su nas informisali da je „sv-
  ježe povrće koje je u ponudi u Konzum prodavni-
  cama većim dijelom domaćeg porijekla, uzgojeno u
  hercegovačkim poljima, Lijevče polju, Semberiji i u
  okolini Tuzle“.
  Prema riječima Tatjane Raković iz Službe za odnose s
  javnošću banjalučkog Merkatora i u ovom trgov-
  ačkom centru je povrće domaćeg porijekla.
  „Mercator Banja Luka u skladu sa visokim stan-
  dardima poslovanja, a u cilju zaštite svojih
  potrošača, svakodnevno vrši sve potrebne kontrole
  proizvoda prije njihovog dospijevanja na police. U
  aktuelnoj sezoni sve sezonsko povrće koje imamo
  je iz domaće proizvodnje. Mercator ima odličnu
  saradnju sa domaćim dobavljačima i
  proizvođačima, a kvalitet i ispravnost robe je im-      liko ﬁrmi iz 21 zemlje.                              mirati u sakladu sa dostupnim uputama stručn-
  perativ za ulazak na police naših trgovina“, dostavl-   Po podacima te ruske agencije odgovorne za veteri-   jaka, te na taj način lično uticati na smanjivanje
  jeno nam je u odgovoru.                                 narsku kontrolu uvoznih proizvoda, zbog epi-         potencijalnih rizika, svoje preporuke
                                                          demije EHEC u Evropi, uvedena je pojačana            potrošačima uputio je i Ombudsman za zaštitu
  Kriza ne jenjava                                        kontrola 64 prerađivača mesa iz 21 zemlje, među      potrošača BiH:
  S obzirom da smo po svemu sudeći tek na početku         kojima je 19 ﬁrmi iz pet zemalja EU.                 l Obavezno prati ruke prije jela i prije pripre-
  krize, mnoge zemlje su uvele dodatne mjere opreza                                                            manja namirnica. Voda mora biti čista.
  pri uvozu svih prehrambenih artikala.                   Preporuke potrošačima                                l Namirnice treba dobro skuvati ili prepeći, a
  Ruska Federalna služba za ﬁtosanitarni i veteri-        U Bosni i Hercegovini, osim Agencije za bezb-        one koje se jedu sirove - temeljno oprati.
  narski nadzor je zbog epidemije izazvane pato-          jednost hrane koja ističe da svoju ulogu imaju i     l Osoba koja barata s hranom mora biti zdrava.
  genim sojem bakterije Ešerihija koli između             potrošači koji moraju vršiti odabir, rukovati s      l Koristiti svježu hranu iz vlastitog podneblja -
  ostalog uvela i ograničenja za uvoz mesa iz neko-       hranom na ispravan način, skladištiti je i konzu-    najbolja je formula zdravog i jeinog obroka.
                                                                                                               l Organske namirnice su skuplje, ali je velika
                                                                                                               njihova dobrobit za zdravlje ljudi.
                                                                                                               l Važno je slušati svoje tijelo i razumjeti svoj
                                                                                                               metabolizam, umjereno jesti te redovno vježbati.
                                                                                                               l Zdrava hrana kao takva ne postoji, postoji
                                                                                                               samo zdravstveno ispravna hrana, a prehrana,
                                                                                                               da bi imala pozitivne efekte na naše zdravlje,
                                                                                                               treba biti prije svega odgovarajuća. A takvu
                                                                                                               pravilnu ili odgovarajuću prehranu deﬁnišu za-
                                                                                                               pravo samo dvije riječi: raznovrsnost i prava
                                                                                                               mjera. Ukratko, možemo jesti sve, ali umjereno. I
                                                                                                               još jedno važno načelo kojeg bi se trebalo držati
                                                                                                               jeste da organizam želi i treba hranu svog pod-
                                                                                                               neblja.
                                                                                                               l Važno načelo pravilne prehrane jeste i da se
                                                                                                               svaki obrok priprema ex tempore, što znači da je
                                                                                                               svjež i pripremljen uoči konzumacije te da nema
                                                                                                               podgrijavanja.
                                                                                                               l Kada neko ima probavne smetnje ili druge
                                                                                                               simptome koje može povezati s hranom,
                                                                                                               svakako treba odmah reagovati i obratiti se
                                                                                                               ljekaru.

                                                                                                                                          BHPotrošač| 5

Dokument ističe različite aspekte ljeta u Banjaluci, uključujući kulturne, sportske i zabavne događaje. Također se osvrće na mogućnosti opuštanja i zabave u lokalnim prirodnim izletištima, a naglašava i važnost zajedništva i druženja. Za kraj, promoviraju se razne aktivnosti poput ljetnog kursa francuskog jezika, evropskog prvenstva u kajaku i kanuu, te muzičkih festivala.